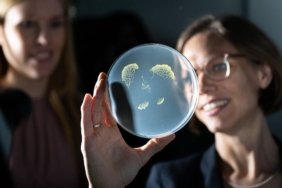

Trending on Billboard
Hatchie is strapped into the Carousel.
On the eve of another United States run, and the announcement of new shows closer to home, the Australian dream-pop practitioner drops “Carousel,” the latest single from her third studio album Liquorice.
“Carousel” explores themes of fixation, longing and emotional suspension, all of it dripping in shoegaze and swirling guitars, almost thick enough to touch. Stream it below.
Hatchie is the project of Melbourne-based, Brisbane-raised singer-songwriter Harriette Pilbeam. And she has come out firing in the New Year.
In support of Liquorice, she plays the Lodge Room this evening, Feb. 5, in Los Angeles, followed by a show Feb. 20 at New York’s Music Hall of Williamsburg. She’ll return to Sydney for a headline show May 3 at The Vanguard, as part of The Great Southern Nights 2026, a weeks-long lineup across New South Wales that includes Paul Kelly, Missy Higgins, Thelma Plum, Jet, 3% and many others.
As previously reported, Hatchie features on the new Yo Gabba GabbaLand! Season 2 soundtrack, alongside Santigold, CHVRCHES, Ziggy Marley and Sharon Van Etten, with her original cut “Movin’ My Body,” now streaming as part of the series on Apple TV+.
“I had never watched YGG but admired from afar,” she tells Billboard. “A Hatchie fan who worked on the show reached out to us about contributing to the soundtrack and we thought it would be a fun project. We were sent a few songs to choose from and instantly clicked with ‘Moving My Body.’”
Liquorice is Hatchie’s first album release through a global deal with Secretly Canadian.
Led off by the singles “Lose It Again,” “Sage,” and “Only One Laughing, the LP was recorded by producer Melina Duterte’s (Jay Som) at her home studio in Los Angeles, alongside Stella Mozgawa (Warpaint, Courtney Barnett) on drums, with Alex Farrar (Wednesday, MJ Lenderman) on mixing duties at Asheville’’s Drop of Sun studios, and Greg Obis (Dutch Interior, Slow Pulp, Wishy) mastering in Chicago.
“I can’t wait to finally play my new album to my Australian fans,” Hatchie enthuses. “It feels like forever since I’ve played a show in Sydney and it just feels right to do it with our old friends GAUCI. I’ve been blown away by the response to Carousel and can’t wait to share more sweet moments on the road.”
Hatchie ‘Liquorice Tour’ 2026:
Feb. 5 — Lodge Room, Los Angeles
Feb. 20 — Music Hall of Williamsburg, New York
Feb. 27 — Bergy Ballroom, Melbourne, Victoria (*Sold Out)
May 3 — The Vanguard, Sydney, NSW (*New Show)
April 12 — Empty Bottle, Chicago, IL @ (*New Show)
Tickets at hatchie.net.